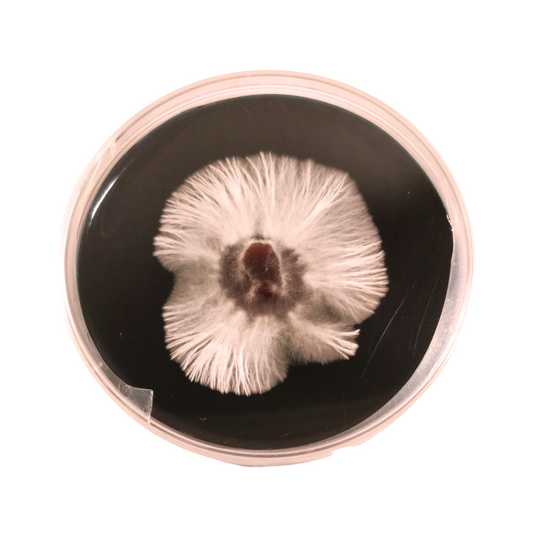

-
Laminar Flow Hood - HEPA filter, Mycology works with high success rates 307x372
Regular price From €245,00 EURRegular priceUnit price / perSale price From €245,00 EUR -
Laminar Flow Hood - HEPA filter, Mycology works with high success rates 410x255
Regular price From €230,00 EURRegular priceUnit price / perSale price From €230,00 EUR -
Lions Mane Liquid Culture - Hericium Erinaceus
Regular price From €11,00 EURRegular priceUnit price / perSale price From €11,00 EUR -
Liquid Culture 3 Pack Pick Any From List Grow Mushrooms + instructions
Regular price From €25,00 EURRegular priceUnit price / perSale price From €25,00 EUR -
Liquid Culture 5 Pack Pick Any From List Grow Mushrooms + Instructions
Regular price From €39,00 EURRegular priceUnit price / perSale price From €39,00 EUR -
Maitake Liquid Culture Mushroom Hen-of-the-woods Grifola frondosa
Regular price From €11,00 EURRegular priceUnit price / perSale price From €11,00 EUR -
Mushroom Culture in Epp tube agar based
Regular price €11,00 EURRegular priceUnit price / perSale price €11,00 EUR -
Mushroom Culture on Petri
Regular price €14,00 EURRegular priceUnit price / perSale price €14,00 EUR -
Mushroom Grain Spawn Golonized Pick Any Strain From The List
Regular price From €24,00 EURRegular priceUnit price / perSale price From €24,00 EUR -
Mushroom Grow Bag 180X350X0.06
Regular price €1,50 EURRegular priceUnit price / perSale price €1,50 EUR -
Mushroom Grow Bag 250X500X0.06
Regular price €1,40 EURRegular priceUnit price / perSale price €1,40 EUR -
Mushroom Grow Bag 320X500X0.06
Regular price €2,00 EURRegular priceUnit price / perSale price €2,00 EUR -
Mushroom Grow Bag 320X650X0.06
Regular price €2,50 EURRegular priceUnit price / perSale price €2,50 EUR -
Mushroom Growing Humidifier – Growing Mushrooms Has Never Been Easier
Regular price From €190,00 EURRegular priceUnit price / perSale price From €190,00 EUR -
Mushroom Growing Kit Sawdust Based
Regular price From €24,00 EURRegular priceUnit price / perSale price From €24,00 EUR -
Mushroom Growing Kit Straw Based
Regular price From €24,00 EURRegular priceUnit price / perSale price From €24,00 EUR